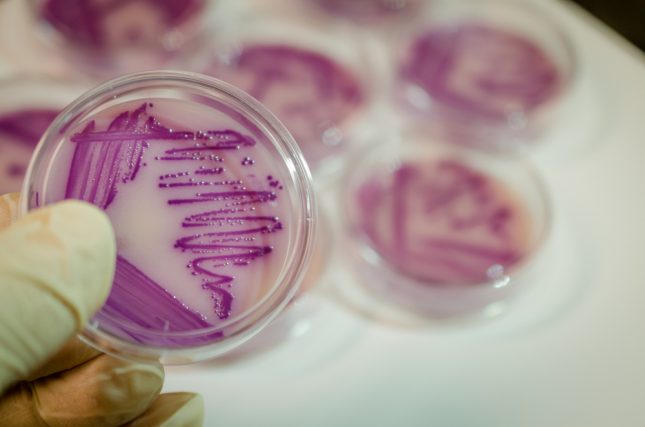

המיקרוביוטיה של העור משחקת תפקיד מפתח בפתוגנזה של מספר מחלות עור, אך תפקידה בצלוליטיס עדיין אינו ידוע. במחקר חדש שנערך באוניברסיטת אמסטרדם והתפרסם בכתב העת Clinical Infectious Diseases, ביקשו החוקרים לחקור את מיקרוביוטת העור של מטופלים עם צלוליטיס, לבדוק האם אנליזה זאת יכולה לסייע בקביעת הפתוגן במחלה, ולבחון האם הרכב מיקרוביוטת העור קשור לתוצאות קליניות.
במחקר נכללו באופן פרוספקטיבי 58 מטופלים שאושפזו עקב צלוליטיס. מטושי עור מהלזיה העורית הושוו עם מטושים במיקום זהה באיבר הקונרה-לטרלי הבריא ועם מטושים שנלקחו מ-19 מקרי ביקורת מתואמים לגיל ולמין ללא צלוליטיס. אפיון של חיידקי מיקרוביוטת העור בוצע באמצעות interspacer profilingי(IS-pro).
החוקרים מצאו שוני בין-אישי גדול בהרכב בהמיקרוביוטיה של העור אצל מטופלים מאושפזים עם צלוליטיס. פירמיקוטים היו הפילום הדומיננטי, ו-Staphylococcus ו-Streptococcus היו הגנרה הדומיננטיים.
ברוב המטופלים, מצאו החוקרים קשר חזק בין המיקרוביוטיה של האיבר החולה לבין המיקרוביוטיה של האיבר הקונטרה-לטרלי הבריא.
בסך הכל, לא היה ניתן להבחין בין הרכב המיקרוביוטיה של הצלוליטיס לבין מיקרוביוטת העור של קבוצת הביקורת. לא נמצא קשר עקבי בין התוצאות של תרביות מסורתיות לבין הרכב מיקרוביוטת העור של המטופלים עם צלוליטיס. בנוסף, החוקרים מצאו שגם הרכב המיקרוביוטיה וגם הגיוון שלה אינם קשורים לפרמטרים קליניים ולתוצאות של מטופלים עם צלוליטיס.
החוקרים מסמכים במחקר ראשוני זו של מיקרוביוטת העור של מטופלים עם צלוליטיס לא זוהה מיקרוביוטה טיפוסית של צלוליטיס. המידע האבחנתי והפרוגנוסטי אשר היה ניתן להפיק מאפיון מיקרוביוטת העור בקרב קבוצת מטופלים זו היה מוגבל.
מקור: